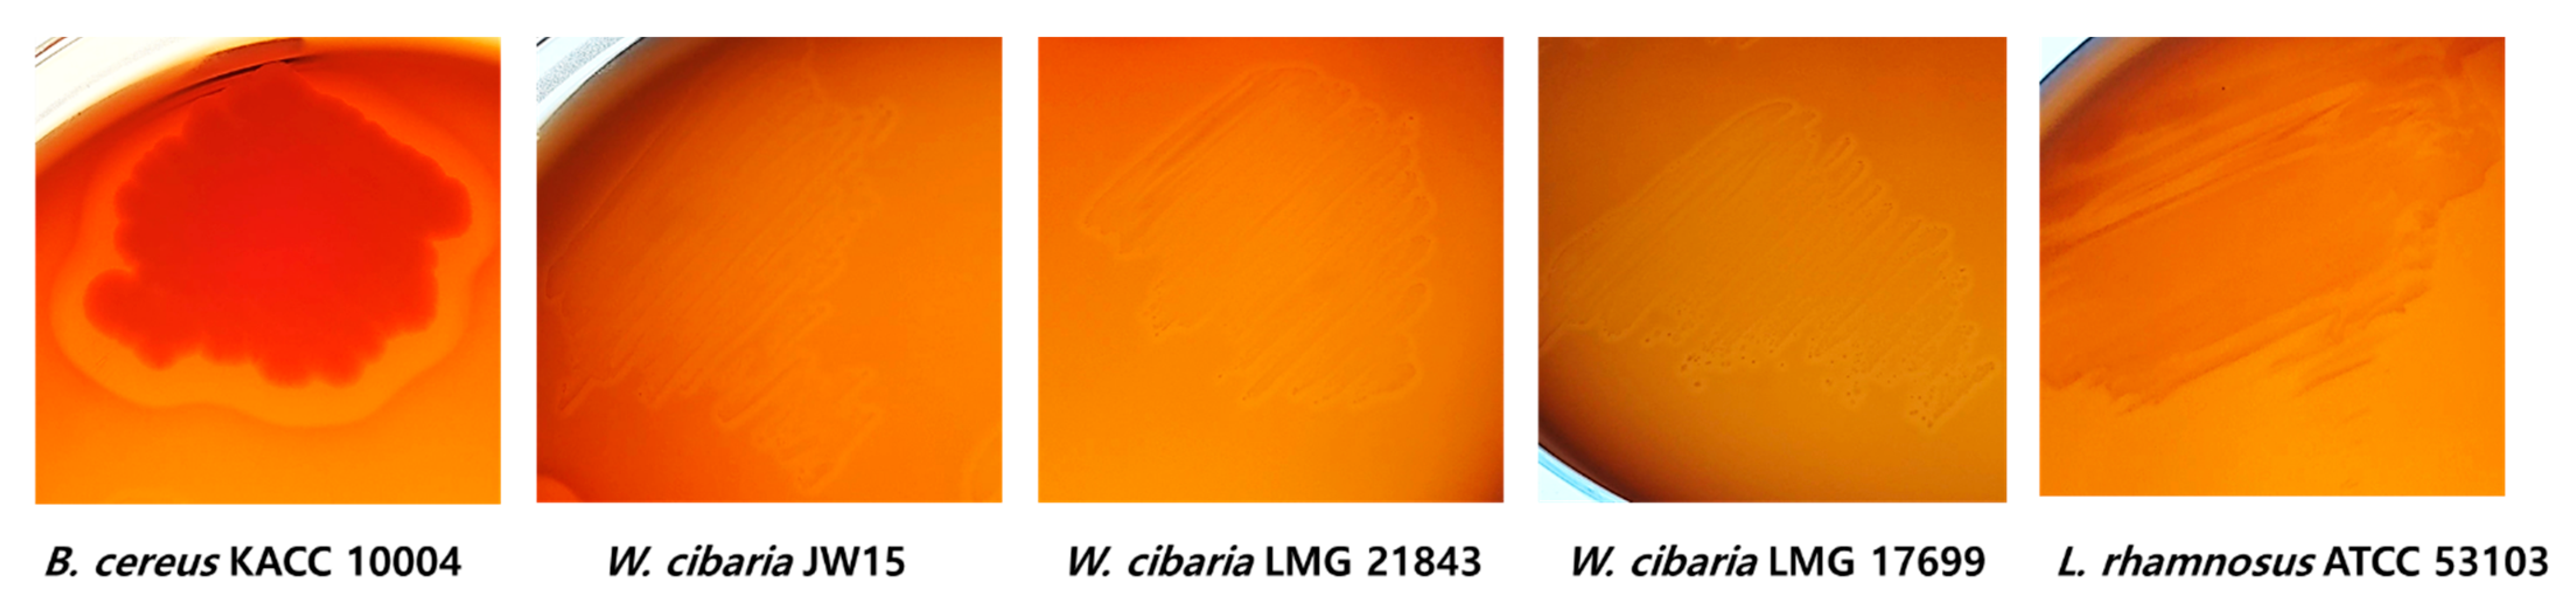
Microorganisms 09 02450 g002

Safety Evaluation of Weissella cibaria JW15 by Phenotypic and Genotypic Property Analysis
Abstract
:1. Introduction
2. Materials and Methods
2.1. Bacterial Strains and Growth Conditions
2.2. Minimum Inhibitory Concentrations on Antibiotics
2.3. Detection of Antibiotic Resistance Genes
2.4. Genomic Analysis
2.5. Bioinformatic Analysis of Virulence Factor-Related Genes
2.6. Hemolytic Activity
2.7. D-Lactic Acid Measurement
2.8. Bile Salt Deconjugation
2.9. Enzymatic Profiles by API ZYM
2.10. Bacterial Reverse Mutation Assay
3. Results and Discussion
3.1. Determination of Minimum Inhibitory Concentrations
3.2. Detection of Antibiotic Resistance Genes
3.3. Genomic Features of JW15 Strain
3.4. Bioinformatic Analysis of VF-Related Genes
3.5. Toxic Metabolite Production
3.5.1. Hemolytic Activity
3.5.2. D-Lactic Acid Production
3.5.3. Bile Salt Deconjugation Test
3.5.4. Enzymatic Profile by API ZYM
3.6. Bacterial Reverse Mutation Assay
Supplementary Materials
Author Contributions
Funding
Institutional Review Board Statement
Informed Consent Statement
Data Availability Statement
Acknowledgments
Conflicts of Interest
References
- Lilly, D.M.; Stillwell, R.H. Probiotics: Growth-promoting factors produced by microorganisms. Science 1965, 147, 747–748. [Google Scholar] [CrossRef]
- Food and Agriculture Organization-World Health Organization (FAO/WHO). Report on Joint FAO/WHO Guidelines for the Evaluation of Probiotics in Food. 2002. Available online: https://www.who.int/foodsafety/fs_management/en/probiotic_guidelines.pdf (accessed on 4 April 2019).
- Anna, Z.-R.; Tyski, S. Are Probiotic Really Safe for Humans? Pol. J. Microbiol. 2018, 67, 251–258. [Google Scholar]
- List of Raw Materials Available for Food. Available online: https://www.foodsafetykorea.go.kr/foodcode/01_03.jsp?idx=12135 (accessed on 4 April 2019).
- Bernardeau, M.; Vernoux, J.P.; Henri-Dubernet, S.; Gueguen, M. Safety assessment of dairy microorganisms: The Lactobacillus genus. Int. J. Food Microbiol. 2008, 126, 278–285. [Google Scholar] [CrossRef] [PubMed]
- Global Market Insights Inc. Probiotics Market Size to Exceed USD 64 Billion by 2023: Global Market Insights Inc. Available online: https://www.prnewswire.com/news-releases/the-global-probiotics-market-size-isexpected-to-reach-usd-66-03-billion-by-2024--300726946.html (accessed on 4 April 2019).
- Liong, M.T. Safety of probiotics: Translocation and infection. Nutr. Rev. 2008, 66, 192–202. [Google Scholar] [CrossRef] [PubMed]
- Hill, C.; Guarner, F.; Reid, G.; Gibson, G.R.; Merenstein, D.J.; Pot, B.; Morelli, L.; Canani, R.B.; Flint, H.J.; Salminen, S.; et al. Expert consensus document. The international scientific association for probiotics and prebiotics consensus statement on the scope and appropriate use of the term probiotic. Nat. Rev. Gastroenterol. Hepatol. 2014, 11, 506–514. [Google Scholar] [CrossRef] [PubMed] [Green Version]
- Ishibashi, N.; Yamazaki, S. Probiotics and safety. Am. J. Clin. Nutr. 2001, 73, 465–470. [Google Scholar] [CrossRef]
- Lee, K.-W.; Park, J.-Y.; Chun, J.-Y.; Han, N.-S.; Kim, J.-H. Importance of Weissella Species during Kimchi Fermentation and Future Works. Microbiol. Biotechnol. Lett. 2010, 38, 341–348. [Google Scholar]
- Rizzello, C.G.; Coda, R.; Wang, Y.; Verni, M.; Kajala, I.; Katina, K.; Laitila, A. Characterization of indigenous Pediococcus pentosaceus, Leuconostoc kimchii, Weissella cibaria and Weissella confusa for faba bean bioprocessing. Int. J. Food. Microbiol. 2019, 302, 24–34. [Google Scholar] [CrossRef]
- Ahn, S.-B.; Park, H.-E.; Lee, S.-M.; Kim, S.-Y.; Shon, M.-Y.; Lee, W.-K. Characteristics and immuno-modulatory effects of Weissella cibaria JW15 isolated from Kimchi, Korea traditional fermented food, for probiotic use. J. Biomed. Res. 2013, 14, 206–211. [Google Scholar] [CrossRef]
- Yu, H.S.; Lee, N.K.; Choi, A.J.; Choe, J.-S.; Bae, C.H.; Paik, H.-D. Antagonistic and antioxidant effect of probiotic Weissella cibaria JW15. Food. Sci. Biotechnol. 2019, 28, 851–855. [Google Scholar] [CrossRef]
- Lee, Y.J.; Lee, A.; Yoo, H.J.; Kim, M.; Noh, G.M.; Lee, J.H. Supplementation with the probiotic strain Weissella cibaria JW15 enhances natural killer cell activity in nondiabetic subjects. J. Funct. Foods 2018, 48, 153–158. [Google Scholar] [CrossRef]
- Bourdichon, F.; Casaregola, S.; Farrokh, C.; Frisvad, J.C.; Gerds, M.L.; Hammes, W.P. Food fermentations: Microorganisms with technological beneficial use. Int. J. Food Microbiol. 2012, 154, 87–97. [Google Scholar] [CrossRef]
- Ouoba, L.I.; Lei, V.; Jensen, L.B. Resistance of potential probiotic lactic acid bacteria and bifidobacteria of african and european origin to antimicrobials: Determination and transferability of the resistance genes to other bacteria. Int. J. Food. Microbiol. 2008, 121, 217–224. [Google Scholar] [CrossRef]
- Kastner, S.; Perreten, V.; Bleuler, H.; Hugenschmidt, G.; Lacroix, C.; Meile, L. Antibiotic susceptibility patterns and resistance genes of starter cultures and probiotic bacteria used in food. Syst. Appl. Microbiol. 2006, 29, 145–155. [Google Scholar] [CrossRef] [PubMed]
- Liu, C.; Zhang, Z.Y.; Dong, K.; Yuan, J.P.; Guo, X.K. Antibiotic resistance of probiotic strains of lactic acid bacteria isolated from marketed foods and drugs. Biomed. Environ. Sci. 2009, 22, 401–412. [Google Scholar] [CrossRef]
- Aquilanti, L.; Garofalo, C.; Osimani, A.; Silvestri, G.; Vignaroli, C.; Clementi, F. Isolation and molecular characterization of antibiotic-resistant lactic acid bacteria from poultry and swine meat products. J. Food Prot. 2007, 70, 557–565. [Google Scholar] [CrossRef] [PubMed]
- Aristimuño Ficoseco, C.; Mansilla, F.I.; Maldonado, N.C.; Miranda, H.; Fátima Nader-Macias, M.E.; Vignolo, G.M. Safety and Growth Optimization of Lactic Acid Bacteria Isolated from Feedlot Cattle for Probiotic Formula Design. Front. Microbiol. 2018, 9, 2220. [Google Scholar] [CrossRef]
- Chin, C.S.; Alexander, D.H.; Marks, P.; Klammer, A.A.; Drake, J.; Heiner, C.; Clum, A.; Copeland, A.; Huddleston, J.; Eichler, E.E.; et al. Nonhybrid, finished microbial genome assemblies from long-read SMRT sequencing data. Nat. Methods 2013, 10, 563–569. [Google Scholar] [CrossRef] [PubMed]
- Walker, B.J.; Abeel, T.; Shea, T.; Priest, M.; Abouelliel, A.; Sakthikumar, S.; Cuomo, C.A.; Zeng, Q.; Wortman, J.; Young, S.K.; et al. Pilon: An integrated tool for comprehensive microbial variant detection and genome assembly improvement. PLoS ONE 2014, 9, e112963. [Google Scholar] [CrossRef]
- Seemann, T. Prokka: Rapid prokaryotic genome annotation. Bioinformatics 2014, 30, 2068–2069. [Google Scholar] [CrossRef]
- Jones, P.; Binns, D.; Chang, H.Y.; Fraser, M.; Li, W.; McAnulla, C.; McWilliam, H.; Maslen, J.; Mitchell, A.; Nuka, G.; et al. InterProScan 5: Genome-scale protein function classification. Bioinformatics 2014, 30, 1236–1240. [Google Scholar] [CrossRef] [Green Version]
- Camacho, C.; Coulouris, G.; Avagyan, V.; Ma, N.; Papadopoulos, J.; Bealer, K.; Madden, T.L. BLAST+: Architecture and applications. BMC Bioinform. 2009, 10, 421. [Google Scholar] [CrossRef] [Green Version]
- Huerta-Cepas, J.; Szklarczyk, D.; Forslund, K.; Cook, H.; Heller, D.; Walter, M.C.; Rattei, T.; Mende, D.R.; Sunagawa, S.; Kuhn, M.; et al. eggNOG 4.5: A hierarchical orthology framework with improved functional annotations for eukaryotic, prokaryotic and viral sequences. Nucleic Acids Res. 2016, 44, D286–D293. [Google Scholar] [CrossRef] [Green Version]
- Krzywinski, M.; Schein, J.; Birol, I.; Connors, J.; Gascoyne, R.; Horsman, D.; Jones, S.J.; Marra, M.A. Circos: An information aesthetic for comparative genomics. Genome Res. 2009, 19, 1639–1645. [Google Scholar] [CrossRef] [PubMed] [Green Version]
- Buchfink, B.; Xie, C.; Huson, D.H. Fast and sensitive protein alignment using 447 DIAMOND. Nat. Methods 2015, 12, 59–60. [Google Scholar] [CrossRef]
- Chen, L.; Yang, J.; Yu, J.; Yao, Z.; Sun, L.; Shen, Y.; Jin, Q. VFDB: A reference database for bacterial virulence factors. Nucleic Acids Res. 2005, 33, D325–D328. [Google Scholar] [CrossRef] [PubMed] [Green Version]
- Dashkevicz, M.P.; Feifhner, S.D. Development of a Differential Medium for Bile Salt Hydrolase-Active Lactobacillus spp. Appl. Environ. Microbial. 1989, 55, 11–16. [Google Scholar] [CrossRef] [Green Version]
- OECD. OECD Guideline for the Testing of Chemicals 471, Bacterial Reverse Mutation Test; OECD: Paris, France, 1997. [Google Scholar]
- FAO; WHO. Probiotics in Food: Health and Nutritional Properties and Guidelines for Evaluation; World Health Organization; Food and Agriculture Organization of the United Nations: Rome, Italy, 2006. [Google Scholar]
- Kang, M.-S.; Yeu, J.-E.; Hong, S.-P. Safety Evaluation of Oral Care Probiotics Weissella cibaria CMU and CMS1 by Phenotypic and Genotypic Analysis. Int. J. Mol. Sci. 2019, 20, 2693. [Google Scholar] [CrossRef] [Green Version]
- Wang, J.; Wei, X.; Fan, M. Assessment of Antibiotic Susceptibility within Lactic Acid Bacteria and Coagulase-Negative Staphylococci Isolated from Hunan Smoked Pork, a Naturally Fermented Meat Product in China. J. Food Sci. 2018, 83, 1707–1715. [Google Scholar] [CrossRef]
- Nawaz, M.; Wang, J.; Zhou, A.; Ma, C.; Wu, X.; Moore, J.E.; Millar, B.C.; Xu, J. Characterization and transfer of antibiotic resistance in lactic acid bacteria from fermented food products. Curr. Microbiol. 2011, 62, 1081–1089. [Google Scholar] [CrossRef] [PubMed]
- Muñoz-Atienza, E.; Gómez-Sala, B.; Araújo, C.; Campanero, C.; del Campo, R.; Hernández, P.E.; Herranz, C.; Cintas, L.M. Antimicrobial activity, antibiotic susceptibility and virulence factors of Lactic Acid Bacteria of aquatic origin intended for use as probiotics in aquaculture. BMC Microbiol. 2013, 13, 15. [Google Scholar] [CrossRef] [PubMed] [Green Version]
- Sharma, P.; Tomar, S.K.; Goswami, P.; Sangwan, V.; Singh, R. Antibiotic resistance among commercially available probiotics. Int. Food Res. J. 2014, 57, 176–195. [Google Scholar] [CrossRef]
- Kim, M.J.; Ku, S.; Kim, S.Y.; Lee, H.H.; Jin, H.; Kang, S.; Li, R.; Johnston, T.V.; Park, M.S.; Ji, G.E. Safety Evaluations of Bifidobacterium bifidum BGN4 and Bifidobacterium longum BORI. Int. J. Mol. Sci. 2018, 19, 1422. [Google Scholar] [CrossRef] [PubMed] [Green Version]
- Tenea, G.N.; Hurtado, P. Next-Generation Sequencing for Whole-Genome Characterization of Weissella cibaria UTNGt21O Strain Originated from Wild Solanum quitoense Lam. Fruits: An Atlas of Metabolites With Biotechnological Significance. Front. Microbiol. 2021, 12, 675002. [Google Scholar] [CrossRef]
- Monshupanee, T. Increased bacterial hemolytic activity is conferred by expression of TlyA methyltransferase but not by its 2′-O-methylation of the ribosome. Curr. Microbiol. 2013, 67, 61–68. [Google Scholar] [CrossRef]
- Beecher, D.J.; Schoeni, J.L.; Wong, A. Enterotoxic activity of hemolysin BL from Bacillus cereus. Infect. Immun. 1995, 63, 4423–4428. [Google Scholar] [CrossRef] [Green Version]
- Vitetta, L.; Coulson, S.; Thomsen, M.; Nguyen, T.; Hall, S. Probiotics, D-lactic acidosis, oxidative stress and strain specificity. Gut Microbes 2017, 8, 311–322. [Google Scholar] [CrossRef] [Green Version]
- Heavey, P.M.; Rowland, I.R. Microbial-gut interactions in health and disease. Gastrointestinal cancer. Best Pract. Res. Clin. Gastroenterol. 2004, 18, 323–336. [Google Scholar] [CrossRef]
- Ames, B.N.; Durston, W.E.; Yamasaki, E.; Lee, F.D. Carcinogens are mutagens: A simple test system combining liver homogenates for activation and bacteria for detection. Proc. Natl. Acad. Sci. USA 1973, 70, 2281. [Google Scholar] [CrossRef] [Green Version]
- Chiu, Y.J.; Nam, M.K.; Tsai, Y.T.; Huang, C.C.; Tsai, C.C. Genotoxicity assessment of multispecies probiotics using reverse mutation, mammalian chromosomal aberration, and rodent micronucleus tests. Sci. World J. 2013, 254239. [Google Scholar] [CrossRef] [Green Version]
- Lin, Y.C.; Chen, Y.T.; Chen, M.J. Lack of mutagenicity, genotoxicity and developmental toxicity in safety assessment tests of Lactobacillus mali APS1. PLoS ONE 2018, 13, e0208881. [Google Scholar] [CrossRef] [PubMed] [Green Version]
- Lu, H.; Zhao, W.; Liu, W.H.; Sun, T.; Lou, H.; Wei, T.; Hung, W.L.; Chen, Q. Safety Evaluation of Bifidobacterium lactis BL-99 and Lacticaseibacillus paracasei K56 and ET-22 in vitro and in vivo. Front. Microbiol. 2021, 12, 686541. [Google Scholar] [CrossRef] [PubMed]

| Anti Biotics | Target Genes | Sequences (5′-3′) | Tm (°C) | Amplicon Size (bp) | |
|---|---|---|---|---|---|
| F | R | ||||
| Streptomycin | aadA | ATCCTTCGGCGCGATTTTG | GCAGCGCAATGACATTCTTG | 53 | 282 |
| aadE | ATGGAATTATTCCCACCTGA | TCAAAACCCCTATTAAAGCC | 53 | 565 | |
| strB | ATCGTCAAGGGATTGAAACC | GGATCGTAGAACATATTGGC | 55 | 509 | |
| Tetracycline | tet(K)-1 | TCGATAGGAACAGCAGTA | CAGCAGATCCTACTCCTT | 51 | 169 |
| tet(K)-2 | TTATGGTGGTTGTAGCTAGAAA | AAAGGGTTAGAAACTCTTGAAA | 52 | 348 | |
| tet(K)-3 | TTAGGTGAAGGGTTAGGTCC | GCAAACTCATTCCAGAAGCA | 55 | 697 | |
| Kanamycin | aph(3″)-III | GCCGATGTGGATTGCGAAAA | GCTTGATCCCCAGTAAGTCA | 57 | 292 |
| ant(2″)-I | GGGCGCGTCATGGAGGAGTT | TATCGCGACCTGAAAGCGGC | 61 | 329 | |
| Clindamycin | lnu(A) | GGTGGCTGGGGGGTAGATGTATTAACTGG | GCTTCTTTTGAAATACATGGTATTTTTCGATC | 59 | 323 |
| Inu(B) | CCTACCTATTGTTTGTGGAA | ATAACGTTACTCTCCTATTTC | 52 | 925 | |
| Gene Information | |||||
| JW15-1_1_00598 | MLKKLGLTAGALAIAIGGTVWFVQNRDAQTATASGELRVVTTNSILEDMVEQVGGDDVSVYSIVKRGTDPHEYEPKTA DITATTEANVIFHNGLNLETGGNGWFSKLTKTANKRDNQEVFSASRLVEPLFLTSKGKEDEMDPHAWLDLNNGIKYV KTITNVLKDKDPEHAQAFQKRSDAYIAKLRALHNEAKDKFADVPVEKRLLVTSEGAFKYFSKVYGIQPAFIWEINTESQ GTPEQMKQVLAKIAASNVKSLFVESSVSPKSMEKVSKETGLPIYEKIYTDSLAKKGTTWDTYYDMV | ||||
| JW15-1_1_00853 | MAIEKERVDVLAVQQGLFTSREQAKRAIMAGEILGENEQRMDKAGEKIPVTTELHLKGAPMPYVSRGGFKLEKALEVF DISVQDKVVLDIGSSTGGFTDVSLQNGAKLVYALDVGTNQLVWKLRSDERVVVMENTNFRYSEPTDFTHGQPAVATID VSFISLNLILPPLAKILTPGGSVATLIKPQFEAGREAIGKHGIVKDATTHLAVLDKVAGYAQAAGFSIVALDYSPIKGGSG NIEFLAHLVLDGGESTMTEAEREAVVTRAHAQLNVRREENADETK | ||||
| Strains | Microbiological Cut-Off Values (mg/L) of Antibiotics | Ref. | ||||||||
|---|---|---|---|---|---|---|---|---|---|---|
| AM | CL | CM | EM | GM | KM | SM | TC | VA | ||
| Leuconostoc spp. | 2 | 4 | 1 | 1 | 16 | 16 | 64 | 8 | N/R | (EFSA a, 2012) |
| W. cibaria JW15 | 0.100 ± 0.000 | 2.300 ± 1.100 | 0.040 ± 0.030 | 0.700 ± 0.400 | 4.500 ± 2.100 | >256 | 56.000 ± 11.300 | 1.800 ± 0.400 | >256 | In this study |
| W. cibaria LMG 21843 | 0.056 ± 0.008 | 2.000 ± 0.000 | 1.000 ± 0.000 | 0.750 ± 0.250 | 6.000 ± 2.000 | >256 | 96.000 ± 0.000 | 1.750 ± 0.250 | >256 | |
| W. cibaria LMG 17699 | 0.095 ± 0.031 | 1.750 ± 0.250 | 0.044 ± 0.021 | 0.875 ± 0.125 | 20.000 ± 4.000 | >256 | 96.000 ± 0.000 | 1.750 ± 0.250 | >256 | |
| L. rhamnosus spp. | 4 | 4 | 1 | 1 | 16 | 64 | 32 | 8 | N/R | (EFSA, 2012) |
| L. rharnnosus GG | 0.285 ± 0.095 | 1.250 ± 0.250 | 0.315 ± 0.185 | 0.235 ± 0.145 | 96.000 ± 0.000 | >256 | 96.000 ± 0.000 | 0.470 ± 0.280 | >256 | In this study |
| Antibiotic | Target Gene | Ref. | W. cibaria JW15 | W. cibaria LMG 21843 | W. cibaria LMG 17699 | L. rharmnosus ATCC 53103 | ||||
|---|---|---|---|---|---|---|---|---|---|---|
| Chromosome | Plasmid | Chromosome | Plasmid | Chromosome | Plasmid | Chromosome | Plasmid | |||
| SM | aadA | [16] | − | − | − | − | − | − | − | − |
| aadE | [20] | − | − | − | − | − | − | − | − | |
| strB | [16] | − | − | − | − | − | − | − | − | |
| TC | tet(K)-1 | [19] | − | − | − | − | − | − | − | − |
| tet(K)-2 | [17] | − | − | − | − | − | − | − | − | |
| tet(K)-3 | [20] | − | − | − | − | − | − | − | − | |
| KM | aph(3″)-III | [16] | − | − | − | − | − | − | − | − |
| ant(2″)-I | [16] | − | − | − | − | − | − | − | − | |
| CM | lnu(A) | [17] | − | − | − | − | − | − | − | − |
| Inu(B) | [18] | − | − | − | − | − | − | − | − | |
| Class | Gene | W. cibaria JW15 | |
|---|---|---|---|
| Contig 1 | Contig 2, 3, 4 | ||
| Enterotoxin | selk, selq, set | − | − |
| Leucotoxin | lukD | − | − |
| Cytolysin | cylA | − | − |
| Cytotoxin K | cytK | − | − |
| Hemolysin | hbl | − | − |
| Gelatinase | gelE | − | − |
| Amino acid decarboxylase | hdc1, hdc2 | − | − |
| tdc | − | − | |
| odc | − | − | |
| ldc | − | − | |
| Hyaluronidase | hyl | − | − |
| Aggregation substance | asa1 | − | − |
| Enterococcal surface protein | esp | − | − |
| Endocarditis antigen | efaA | − | − |
| Adhesion of collagen | ace | − | − |
| Cereulide | cesA | − | − |
| Sex pheromones | ccf, cob, cpd | − | − |
| Serine protease | sprE | − | − |
| Transposon-related genes | int, intTN | − | − |
| BLASTX results against VFDB was filtered based on followed thresholds; | |||
| Coverage 70% | |||
| Percent identity 50% | |||
| Locus Tag | VFDB Reference | NCBI-Nr Database Reference | Uniprot Database Reference | |||
|---|---|---|---|---|---|---|
| Id(%) | Gene Name | Id(%) | Gene Name | Id(%) | Gene Name | |
| JW15-1_1_00598 | 57.4 | (efaA) endocarditis specific antigen | 100 | zinc ABC transporter substrate-binding protein [Weissella cibaria] | 98.7 | SsaB protein (Weissella cibaria) (unreviewed) |
| 51.1 | Metal ABC transporter substrate-binding lipoprotein (Streptococcus pyogenes serotype) (reviewed) | |||||
| JW15-1_1_00853 | 53.1 | putative RNA methyltransferase [Hemolysin (CVF417)] | 100 | TlyA family RNA methyltransferase [Weissella cibaria] | 99.6 | Cell division protein FtsJ (Weissella cibaria) (unreviewed) |
| 86.4 | 23S rRNA (Cytidine1920-2′-O)/16S rRNA (Cytidine1409-2′-O)-methyltransferase (Weissella soli) (unreviewed) | |||||
| Enzymatic Profiles | JW15 | LGG | LMG 21843 | LMG 17699 |
|---|---|---|---|---|
| Alkaline phosphatase | − | − | − | − |
| Esterase (C4) | − | + | − | − |
| Esterase lipase (C8) | − | + | − | − |
| Lipase (C14) | − | − | − | − |
| Leucine arylamidase | + | + | + | + |
| Valine arylamidase | − | + | − | − |
| Cystine arylamidase | − | + | − | − |
| Trypsin | − | − | − | − |
| α-chymotrypsin | − | + | − | − |
| Acid phosphatase | + | + | + | + |
| Naphthol-AS-BI- phosphohydrolase | + | + | + | + |
| α-galactosidase | − | − | − | − |
| β-galactosidase | − | + | − | + |
| β-glucuronidase | − | − | − | − |
| α-glucosidase | − | + | − | − |
| β-glucosidase | − | + | − | + |
| acetyl glucosaminidase | − | − | − | − |
| α-mannosidase | − | − | − | − |
| α-fucosidase | − | + | − | − |
| Toxic metabolic production | ||||
| Hemolysis (beta-) | − | − | − | − |
| D-lactate (nmol/μL) | 0.010 ± 0.006 | 0.000 ± 0.000 | 0.019 ± 0.011 | 0.015 ± 0.007 |
| Bile salt deconjugation | − | − | − | − |
| Dose of W. cibaria JW15 (μg/Plate) | Number of Revertant Colonies per Plate (Mean ± S.D) | ||||
|---|---|---|---|---|---|
| TA98 | TA100 | TA1535 | TA1537 | WP2uvrA | |
| Without S9 mix | |||||
| Negative control a | 20.7 ± 0.9 | 103.7 ± 4.2 | 14.8 ± 0.7 | 8.7 ± 0.5 | 41.2 ± 12.5 |
| 313 | 22.3 ± 0.5 | 106.7 ± 6.1 | 13.3 ± 1.4 | 8.7 ± 2.4 | 42.7 ± 12.3 |
| 625 | 21.8 ± 0.2 | 102.3 ± 2.4 | 15.3 ± 0.5 | 8.3 ± 1.4 | 43.5 ± 12.5 |
| 1250 | 19.5 ± 1.6 | 106.3 ± 5.2 | 13.8 ± 1.6 | 9.5 ± 2.6 | 41 ± 13.2 |
| 2500 | 21.3 ± 1.4 | 101.7 ± 3.3 | 15.5 ± 0.2 | 9.7 ± 0.9 | 40.7 ± 14.1 |
| 5000 | 18.8 ± 1.2 | 105.3 ± 7.5 | 13.8 ± 0.2 | 8.7 ± 1.4 | 40.2 ± 12.5 |
| Positive control b | 566.5 ± 18.1 | 621.2 ± 35.6 | 451.5 ± 0.7 | 440.5 ± 18.1 | 227.5 ± 5.9 |
| With S9 mix | |||||
| Negative control a | 32 ± 0.5 | 112.5 ± 10.6 | 14.2 ± 0.2 | 17 ± 4.2 | 36.3 ± 5.2 |
| 313 | 31 ± 0.5 | 114.7 ± 10.4 | 13.3 ± 0 | 16 ± 4.7 | 35.7 ± 7.1 |
| 625 | 31.7 ± 1.9 | 113.5 ± 13.4 | 14 ± 0.9 | 16.2 ± 5.4 | 36.5 ± 5.9 |
| 1250 | 30.2 ± 0.2 | 111.3 ± 9.4 | 15.5 ± 0.2 | 17 ± 6.6 | 34.8 ± 6.8 |
| 2500 | 32.3 ± 0.9 | 114 ± 10.8 | 15.5 ± 2.1 | 16 ± 6.1 | 36.7 ± 5.7 |
| 5000 | 32.7 ± 0.5 | 110.3 ± 9 | 13.7 ± 0 | 17.3 ± 6.6 | 34.3 ± 6.6 |
| Positive control c | 333.7 ± 46.2 | 667.8 ± 0.2 | 149.3 ± 14.6 | 158.8 ± 17.2 | 454.3 ± 31.1 |
Publisher’s Note: MDPI stays neutral with regard to jurisdictional claims in published maps and institutional affiliations. |
© 2021 by the authors. Licensee MDPI, Basel, Switzerland. This article is an open access article distributed under the terms and conditions of the Creative Commons Attribution (CC BY) license (https://creativecommons.org/licenses/by/4.0/).
Share and Cite
Jang, Y.-J.; Gwon, H.-M.; Jeong, W.-S.; Yeo, S.-H.; Kim, S.-Y. Safety Evaluation of Weissella cibaria JW15 by Phenotypic and Genotypic Property Analysis. Microorganisms 2021, 9, 2450. https://doi.org/10.3390/microorganisms9122450
Jang Y-J, Gwon H-M, Jeong W-S, Yeo S-H, Kim S-Y. Safety Evaluation of Weissella cibaria JW15 by Phenotypic and Genotypic Property Analysis. Microorganisms. 2021; 9(12):2450. https://doi.org/10.3390/microorganisms9122450
Chicago/Turabian StyleJang, Ye-Ji, Hee-Min Gwon, Woo-Soo Jeong, Soo-Hwan Yeo, and So-Young Kim. 2021. "Safety Evaluation of Weissella cibaria JW15 by Phenotypic and Genotypic Property Analysis" Microorganisms 9, no. 12: 2450. https://doi.org/10.3390/microorganisms9122450
APA StyleJang, Y.-J., Gwon, H.-M., Jeong, W.-S., Yeo, S.-H., & Kim, S.-Y. (2021). Safety Evaluation of Weissella cibaria JW15 by Phenotypic and Genotypic Property Analysis. Microorganisms, 9(12), 2450. https://doi.org/10.3390/microorganisms9122450

